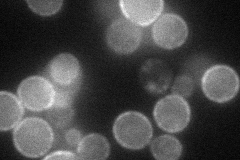
YGR197C
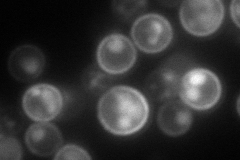
YGR197C
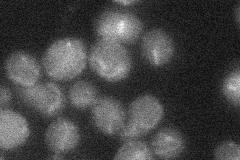
YGR197C
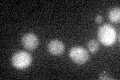
YGR197C

View description
Protein involved in nitrosoguanidine (MNNG) resistance; expression is regulated by transcription factors involved in multidrug resistance
Localization:
Intensity:
Fold change:
Significance:
-
C’ GFP library in SD

below threshold16.38 -
N' NOP1pr-GFP in SD
cell periphery,punctate65.0397 -
N' TEF2pr-mCherry in SD
cell periphery,vacuole108.649 -
N' NATIVEpr-GFP in SD
below threshold23.5709 -
N' TEF2pr-VC and Cyto-VN in SD

cell periphery34.2324 -
C’ GFP library in SD+DTT
cytosol12.690.77No -
C’ GFP library in SD+H2O2

cytosol15.160.92No -
C’ GFP library in Starvation Media

cytosol16.81.02No -
C’ GFP library on the background of Pup2-DaMP

below threshold -
C’ GFP library on the background of CCT mutant

below threshold14.56840.888625No
